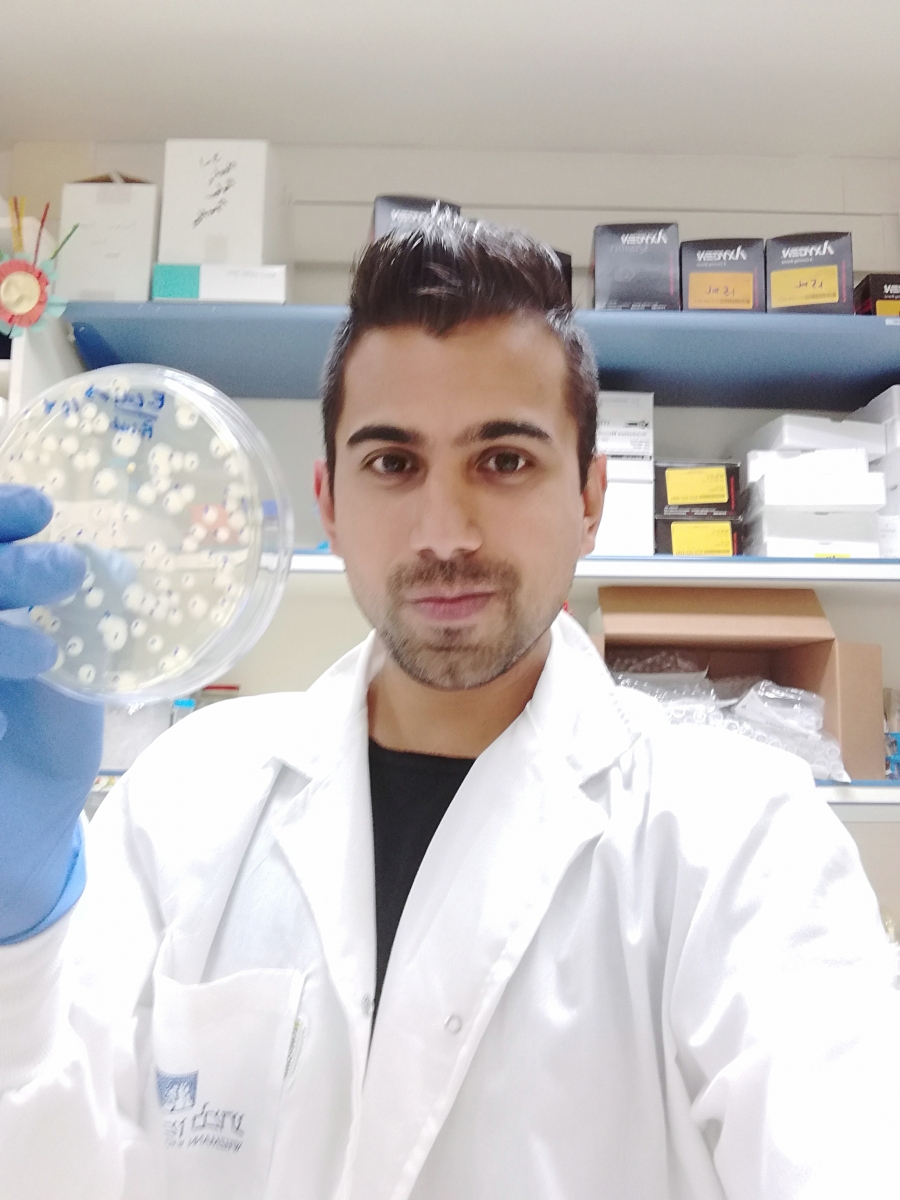

Lab members
| Member`s photo: |
Name: |
Role: |
Email: |
|---|---|---|---|
|
|
Ilana Kolodkin-Gal |
Principal Investigator |
|
|
|
Alona Keren-Paz |
Consultant |
|
|
|
Ronit Suissa |
Ph.D student |
|
|
|
Harsh Maan |
Ph.D student |
|
|
|
Omri Gilhar |
Ph.D student |
|
|
|
Shatha Safadi
|
M.Sc student (In collaboration with Tel-Aviv Medical School) |
|
|
Itamar Efrati
|
Research Projectant (The Koret School of Veterinary Medicine, The Hebrew University) | ||
|
|
Meyer Building Rooms 104 & 117 |
08-934-5167 / 08-934-6981 |
|